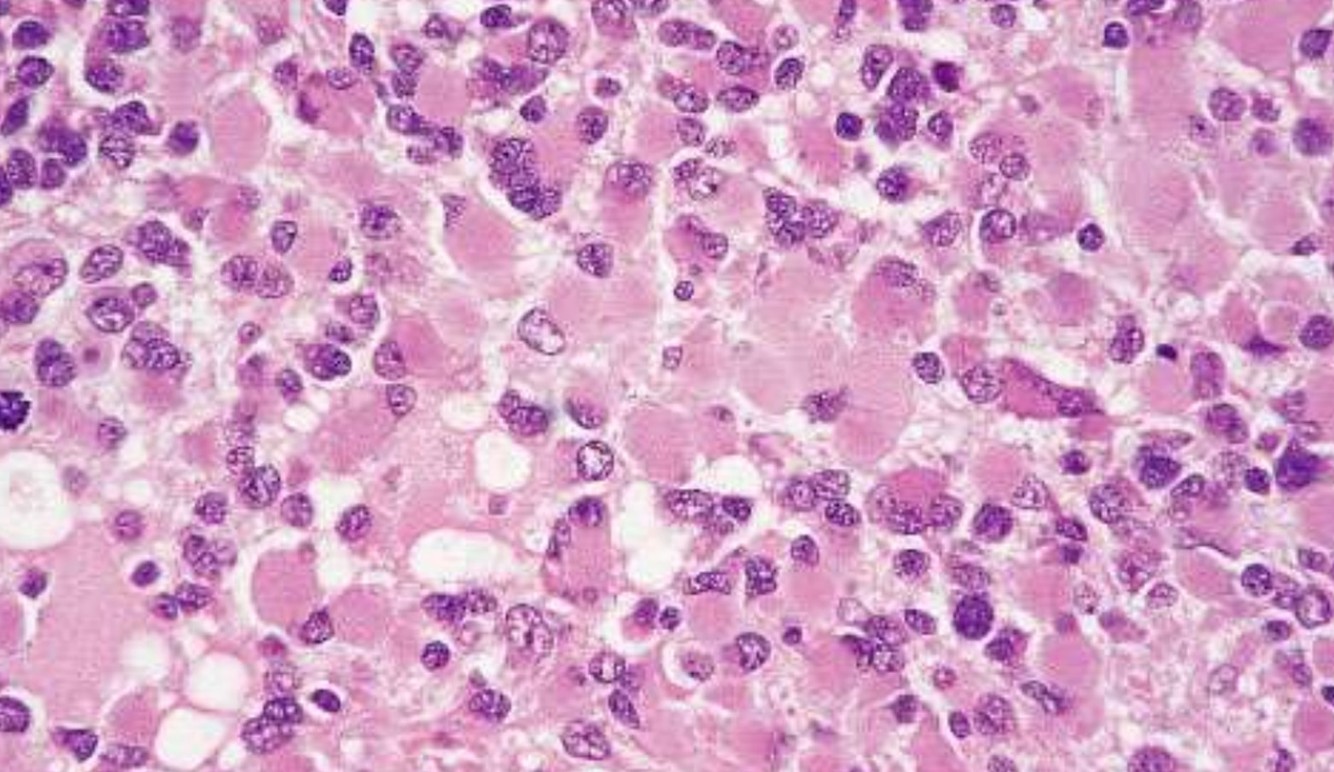

GLIOMAS
GLIOMAS
- Astrocytoma
- Oligodendroglioma
- Ependymoma
Astrocytomas
- Infiltrating
- Non-infiltrating
Astrocytomas
- Infiltrating
- Diffuse astrocytoma
- Anaplastic astrocytoma
- Glioblastoma
- Gliomatosis cerebri
- Non-infiltrating
- Pilocytic astrocytoma
- Pleomorphic xanthosastrocytoma
Infiltrating Astrocytoma
- __% of primary adult tumors
- Location
- Spectrum of histologic grades:
- WHO Grade II:
- WHO Grade III:
- WHO Grade IV:
- Age:
- Diffuse astrocytoma:
- Anaplastic astrocytoma:
- GBM:
- High grade (III and IV): __ therapy
Infiltrating Astrocytoma
- 80% of primary adult tumors
- Cerebral hemispheres most common
- Spectrum of histologic grades:
- WHO Grade II: diffuse astrocytoma
- WHO Grade III: anaplastic astrocytoma
- WHO Grade IV: glioblastoma
- Age:
- Diffuse astrocytoma: 35 y/o
- Anaplastic astrocytoma: 45 y/o
- GBM: 60 y/o
- High grade (III and IV): adjuvant therapy





Glioblastoma, WHO grade IV
Astrocytic Genetics
Astrocytic Genetics
- Low Grade: p53 mutations and over expression of PDGF-A and its receptors
- Isocitrate dehydrogenase I (IDH 1), a metabolic enzyme in the citric acid cycle, is commonly mutated in astrocytomas, oligodendroglioma, and mixed gliomas- low grade (II) and anaplastic (III). Associated with better prognosis.
- Primary Glioblastomas: MDM2 amplification, mutated/ aberrant expression of EGFR/p16 deletion/ PTEN mutation
- Better response to chemotherapy: Methylation of promoter for gene encoding MGMT.
- 10q/PTEN deletion (e.g., whole-arm loss): predominantly astrocytic ‘signature’; comprises independent negative prognostic factor
- EGFR amplification (chromosome 7): evident in ‘primary’ glioblastomas (small-cell cytophenotype); comprises independent negative prognostic factor
Gemistocytic astrocytoma
- p53 positive
- Prone to progress to anaplastic and GBM
Non-infiltrating Astrocytomas
- Pilocytic astrocytoma
- Grade
- Age
- Location
- Genetics
- Pleomorphic xanthosastrocytoma
- Grade
- Age
- Location
Non-infiltrating Astrocytomas
- Pilocytic astrocytoma
- Grade I
- Children and young adult
- Cerebellum, thalamus, optic nerve
- NF1
- Pleomorphic xanthosastrocytoma
- Grade II
- Children and young adults
- Temporal lobe most common

Pilocytic astrocytomas, WHO Grade I
- Biphasic appearance (compact or loose)
- Compact area: Rosenthal fibers
- Age
- Location
- Interval to anaplastic progression
- __ deletion, oligodendroglial ‘signature’; connotes chemosensitivity

Oligodendroglioma
- 5-15% of gliomas
- Age: 40 ~ 50 y/o, rare in children
- Restricted to supratentorial compartment
- Interval to anaplastic progression is longer relative to astrocytoma (range 9y, vs 4-5y for latter)
- 1p, 19q deletion, oligodendroglial ‘signature’; connotes chemosensitivity


Ependymoma
- Incidence: 5% to 10% of primary brain tumors in the 1st two decades
- Arise around ventricular lining
- Locations:
- The 4th ventrical: common in children
- Spinal: adults, mean 40 yrs, NF2
- Loss/mutation of NF2 on chromosome 22q in spinal cord tumors


Neuronal/Glioneuronal Tumors
Neuronal/Glioneuronal Tumors
- Ganglioglioma
- Dysembryoplastic Neuroepithelial tumor (DNT)
- Central Neurocytoma

Ganglioglioma, GI
- Bi-nucleate, dysmorphic neurons
- Low grade astrocytomas
Poorly Differentiated/ Embryonal Tumors
Poorly Differentiated/ Embryonal Tumors
- Malignant small blue cell tumors
- Grade IV
- Young Children
- Based on location:
– Medulloblastoma
– Primitive Neuroectodermal tumor of the Central Nervous System (PNET)
– Atypical Teratoid/ Rhabdoid Tumor (ATRT)

Medulloblastoma
- 20% of pediatric brain tumors
- Posterior fossa
- Spreads by CSF seeding along the subarachnoid space

Primitive Neuroectodermal Tumor
- Supratentorial tumors
- Histologically identical to medulloblastomas, genetically differ from medulloblastomas and peripheral PNET (lack Ewing’s translocations)
- Homer-Wright rosette



Atypical Teratoid/Rhabdoid tumor
- 2% of pediatric brain tumors
- Highly malignant of young children/infants (up to 5 years of age)
- “Rhabdoid” cells
- Multiple lineage markers (epithelial , muscle)
- Molecular Genetics: >90% of cases show loss/mutations of hSN5/INI1 gene on chromosome 22
- IHC: loss of normal nuclear staining for INI1

Meningioma
- Benign tumors of adults
- Locations:
- Attached to dura, arise from arachnoid meningothelial cells
- Intraventricular, arise from stromal arachnoid cells of choroid plexus
- Slight female predominance (3:2)
- Often express progesterone receptors
- Rapid growth during pregnancy
- Cytogenetics
- loss of chromosome 22q
- Multiple meningiomas associated with NF2

Meningioma Grades and subtypes
Meningioma Grades and subtypes
- Grade I (92%): most common, “cure” possible with complete resection
- Meningothelial, fibrous, transitional, psammomatous, angiomatous, microcystic, secretory, lymphoplasmacyte-rich, mataplastic
- Grade II (7%): higher rate of recurrence
- Atypical, clear cell, chordoid
- Grade III (rare): highly aggressive
- Anaplastic, rhabdoid, papillary

Anaplastic Meningioma

Clear Cell Meningioma
































